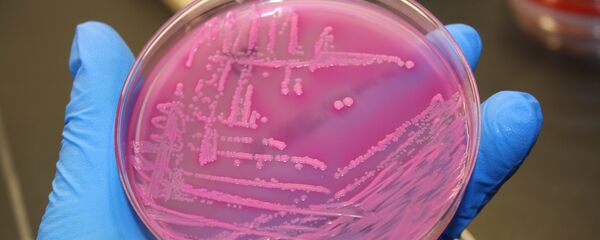
a bactéria E. coli - Sputnik Brasil

"Quero tranquilizar os portugueses, e sobretudo a região Norte, dizendo que as entidades ligadas ao ciclo urbano da água estão muito atentas a esta situação e, caso haja risco para a saúde pública, não deixaremos de atuar tomando as medidas adequadas", cita o jornal Diário de Noticias as palavras do secretário de Estado.
Foram descobertas quatro estripes de bactérias multirresistentes no rio Ave do tipo “Escherchia coli”, o que significa que têm um grande grau de resistência aos antibióticos. Considerando que essas bactérias são desconhecidas, e que as mesmas não tinham sido observadas até ao momento, este caso provoca um grande interesse dos cientistas e esse aparecimento já obteve o nome de “mistério do rio Ave”.
Segundo Martins, os cientistas se mostram perplexos com a descoberta. Estas bactérias ainda têm que ser examinadas pelos cientistas, mas os conhecimentos de hoje não permitem classificá-los como perigosos para a humanidade.